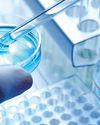
Bottleneck in drug testing: Sri Lanka's bioequivalence challenge30

Try GOLD - Free
Daily FT - June 03, 2025

Go Unlimited with Magzter GOLD
Read Daily FT along with 10,000+ other magazines & newspapers with just one subscription
View CatalogSubscribe only to Daily FT
Cancel Anytime.
(No Commitments) ⓘIf you are not happy with the subscription, you can email us at help@magzter.com within 7 days of subscription start date for a full refund. No questions asked - Promise! (Note: Not applicable for single issue purchases)
Digital Subscription
Instant Access ⓘSubscribe now to instantly start reading on the Magzter website, iOS, Android, and Amazon apps.
Verified Secure
payment ⓘMagzter is a verified Stripe merchant.
In this issue
June 03, 2025
Daily FT Description:
Daily FT:National English Daily:authoritative market and financial news for business www.ft.lk
Recent issues

December 03, 2025

December 02, 2025

December 01, 2025

November 29, 2025

November 28, 2025

November 27, 2025

November 26, 2025

November 25, 2025

November 24, 2025

November 22, 2025

November 21, 2025

November 20, 2025

November 19, 2025

November 18, 2025

November 17, 2025

November 15, 2025

November 14, 2025

November 13, 2025

November 12, 2025

November 11, 2025

November 10, 2025

November 08, 2025

November 07, 2025

November 06, 2025

November 05, 2025

November 04, 2025

November 03, 2025

November 01, 2025

October 31, 2025

October 30, 2025
Related Titles

The Island

Sunday Island

Daily Mirror - Sri Lanka

The Washington Post

New York Amsterdam News

Los Angeles Times

Business Standard

Hindustan Times

Mint Mumbai

The Morning Standard

The Free Press Journal

Financial Express Delhi

The New Indian Express

The Statesman

Millennium Post Delhi

Hindustan Times Mumbai

The Business Guardian

Hindustan Times Bengaluru

Hindustan Times Pune

Hindustan Times Chandigarh

Hindustan Times Lucknow

Hindustan Times Gurugram

Hindustan Times Patna

Hindustan Times Noida

Hindustan Times Jaipur

Hindustan Times Ranchi

Hindustan Times East UP

Hindustan Times Ludhiana

Hindustan Times Navi Mumbai

Hindustan Times Uttarakhand